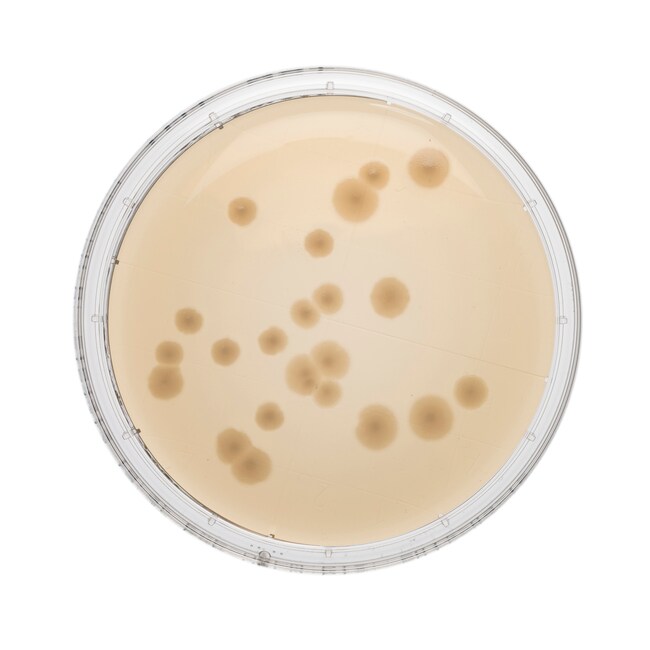
Tryptone Soya Agar Irradiated Triple Wrap Contact Plate

Search
Thermo Scientific™
Tryptone Soya Agar Irradiated Triple Wrap Contact Plate
Perform effortless surface sampling in the most regulated environments using this Triple Wrapped Irradiated Contact Plate.
货号 PO0262D
价格(CNY)
-
Perform effortless surface sampling in the most regulated environments using Thermo Scientific™ Oxoid™ Tryptone Soya Agar Irradiated Triple Wrap Contact Plate. Tryptone Soya Agar is a general purpose medium containing two peptones. It supports the growth of wide variety of organisms and is suitable for the cultivation of both aerobes and anaerobes.
Streamline environmental monitoring of cleanroom environments with Tryptone Soya Agar Irradiated Triple Wrap Contact Plate.
- Secure: dome-shaped bottom prevents agar from falling out of the dish
- Easy-to-handle: GripFit™ technology ensures the lid remains in place during handling while being easily removed during environmental monitoring
- Straightforward results interpretation: inner layer on the plate base is sub-divided into grids to allow easy calculation of colony forming units (CFU) from surface tests, enabling labs to report whether contaminant levels fall within pre-defined acceptable limits
- Easy-to-stack: provides more stability during handling and transport, and ventilation is reduced to prevent plates from drying out
- Consistent: manufactured using a specialized, automated procedure to ensure a smooth, evenly distributed layer of agar on each plate
- Contamination risk reduction: protective layers enhance moisture control by incorporating novel elements that permit the passage and absorption of excess moisture, reducing the risk of contamination
Not all products are available for sale in all territories. Please inquire.
Remel™ and Oxoid™ products are now part of the Thermo Scientific brand.
规格
颜色透明秸秆
描述Tryptone Soya Agar Triple Wrap Irradiated Contact Plate
容纳重量13.5g ± 5 %
产品规格55mm Contact Plate
包装类型Triple Wrapped - Irradiated
数量10/Pk.
有效期14 Weeks
原料来源英国
产品类型Agar Plate
Unit SizeEach
内容与储存
2 至 25°C